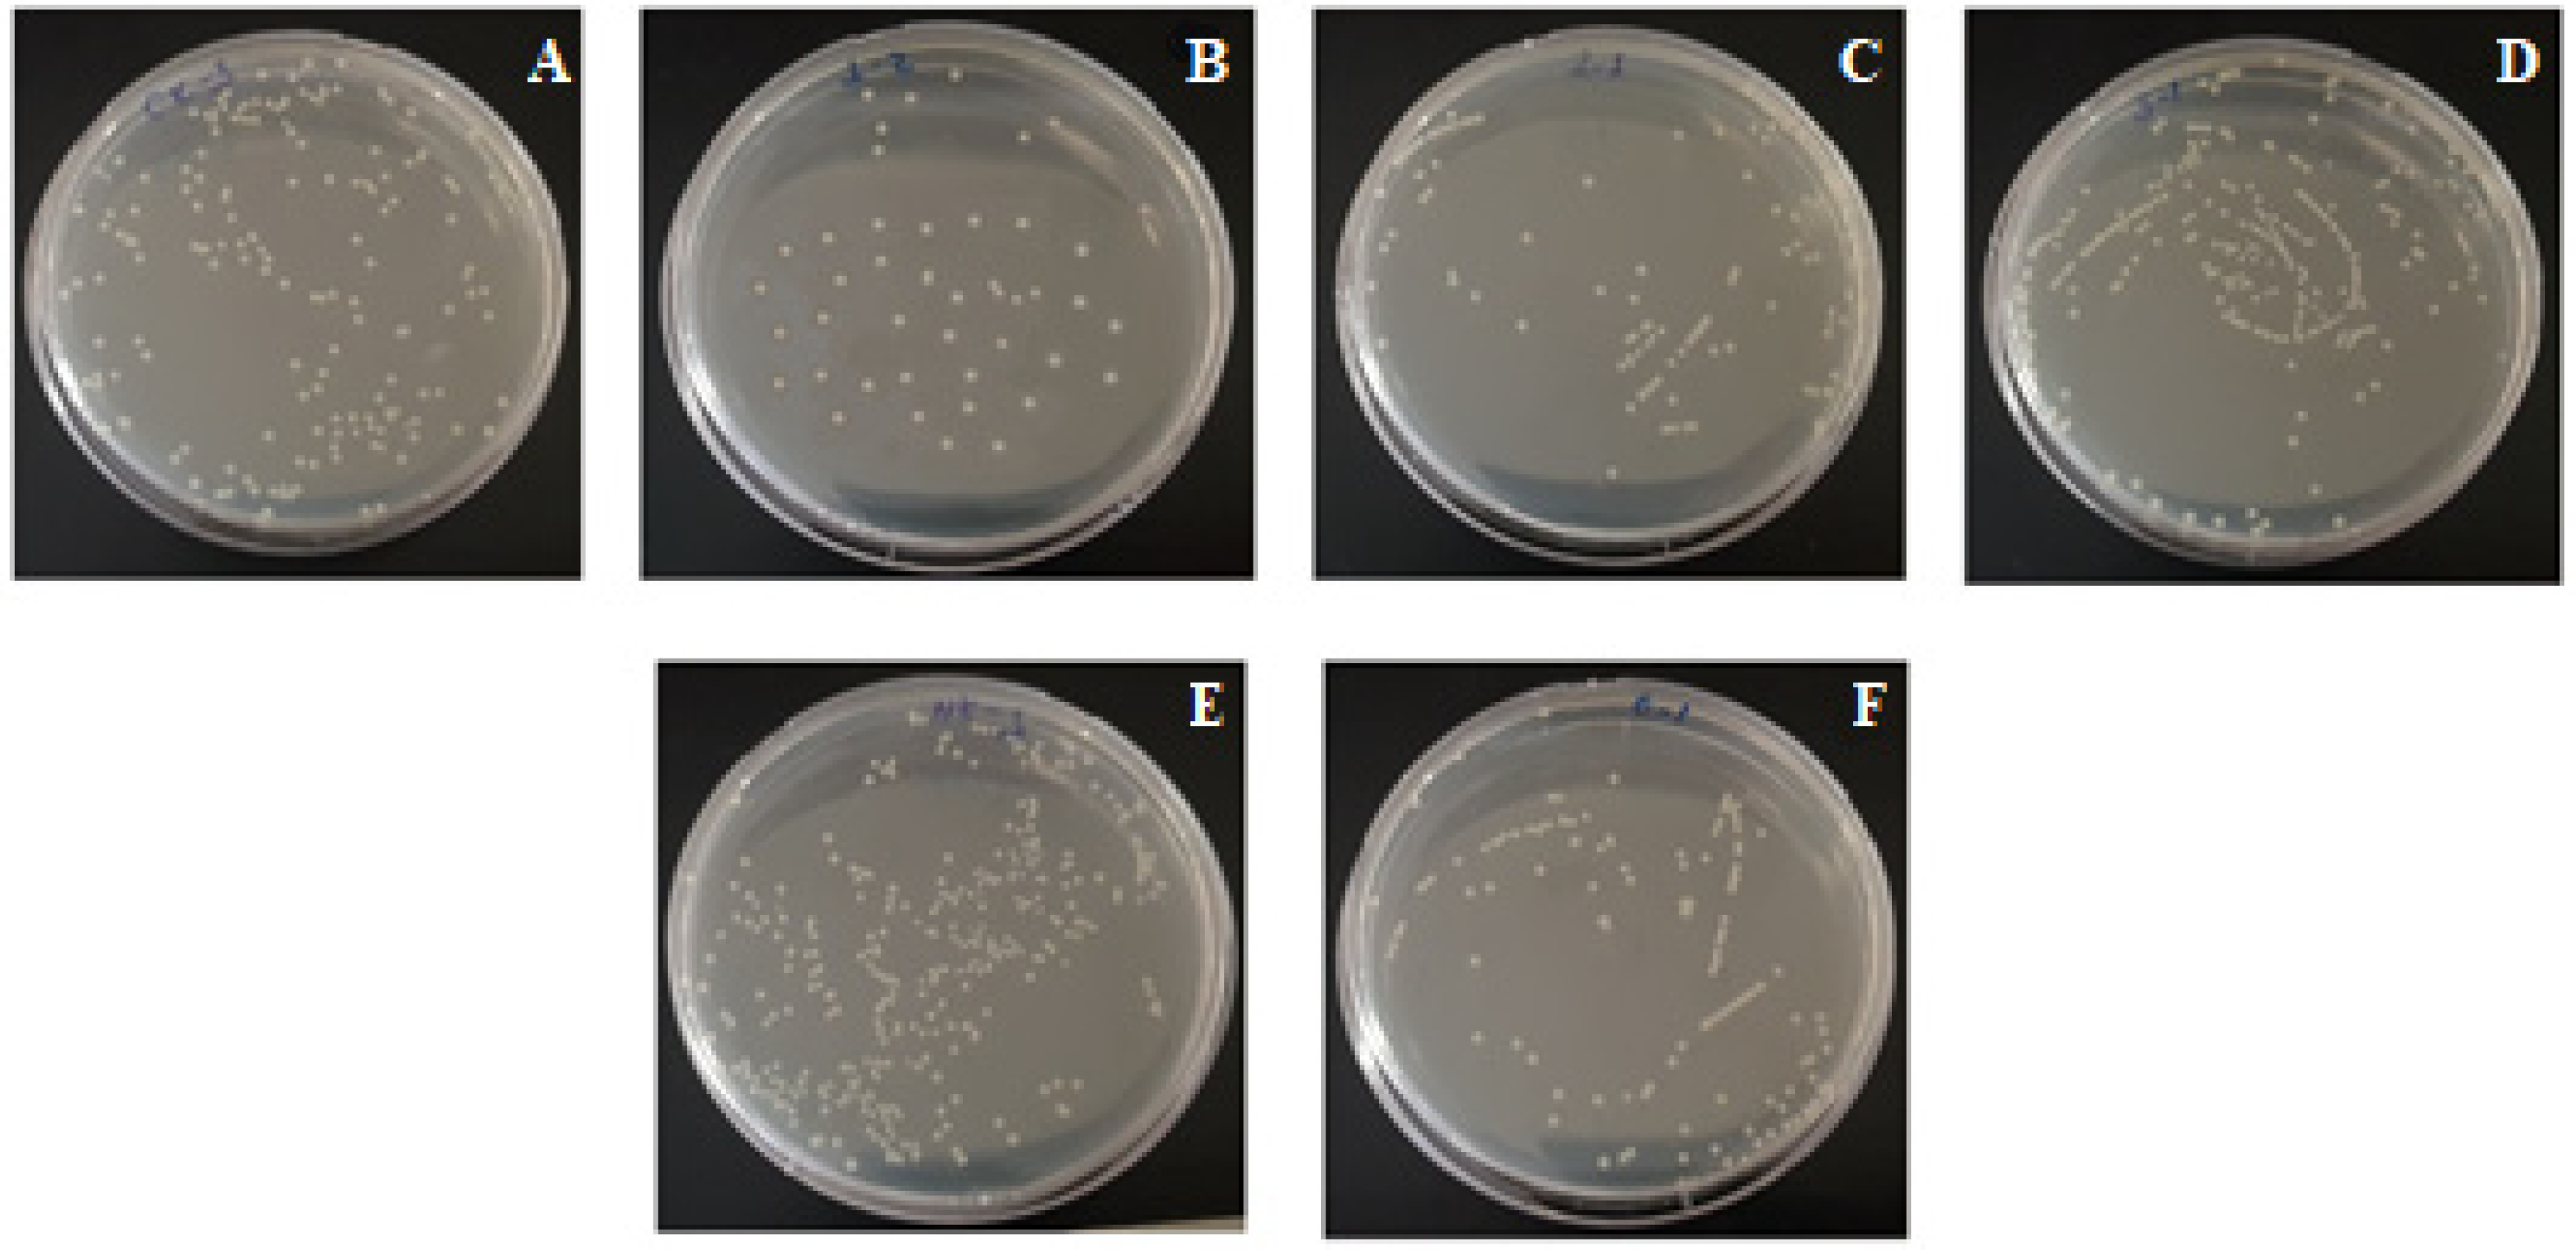
Applsci 11 07922 g009 550
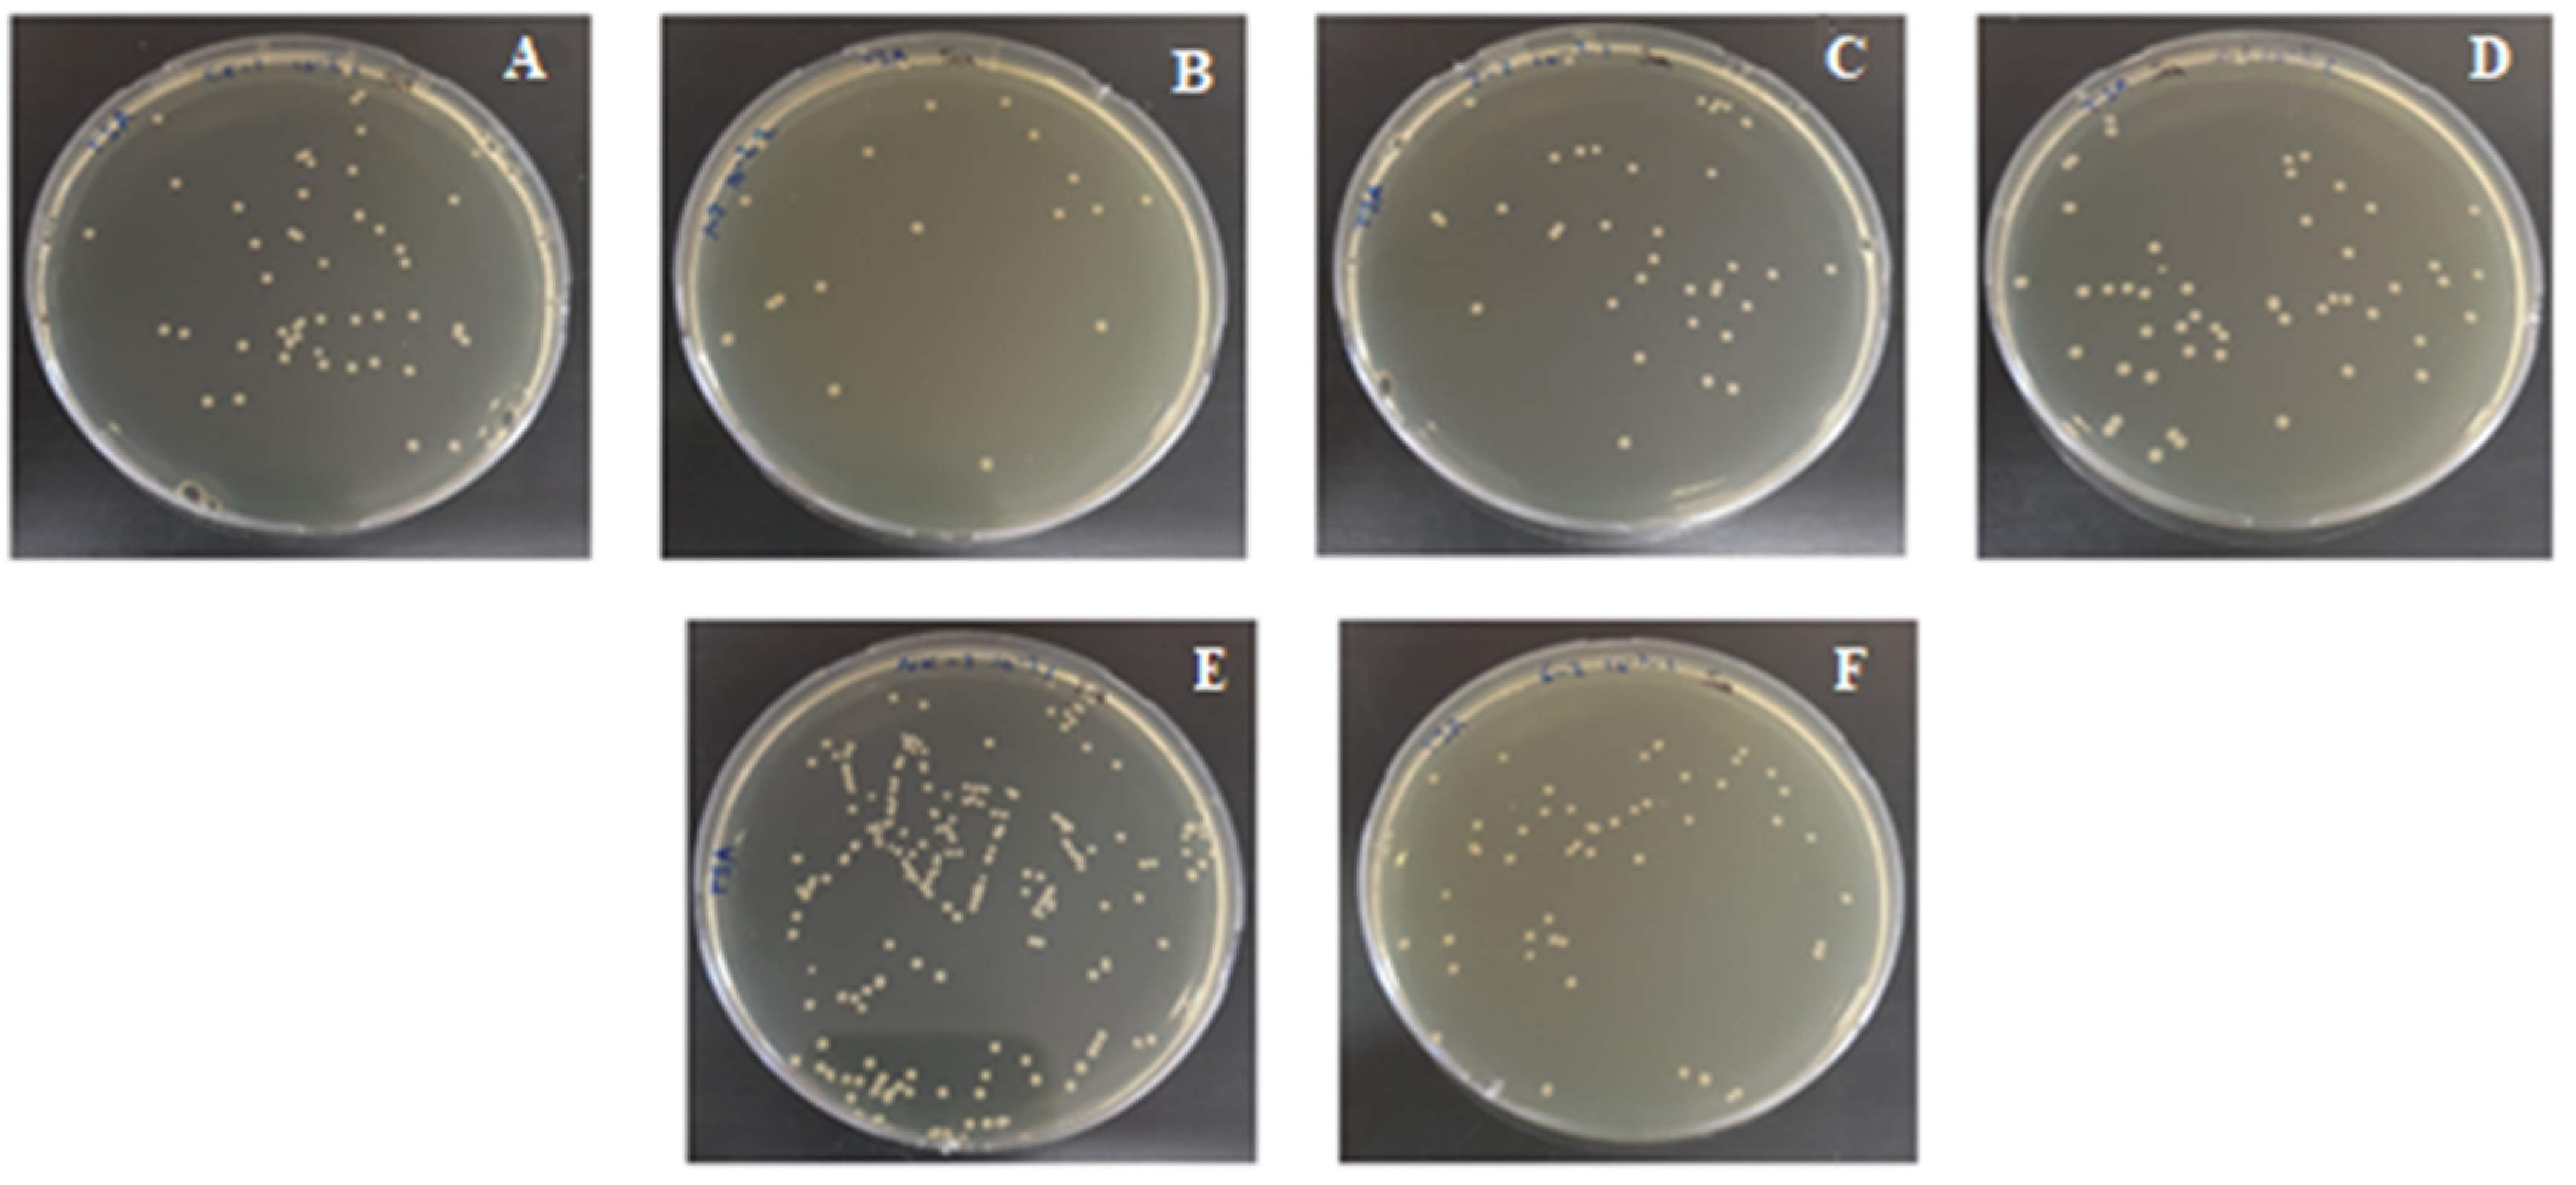
Applsci 11 07922 g010 550

Antibacterial Efficiencies of CVD-PECVD Graphene Nanostructures Synthesized onto Glass and Nickel Substrates against Escherichia coli and Staphylococcus aureus Bacteria
Abstract
:Featured Application
Abstract
1. Introduction
2. Materials and Methods
2.1. Synthesis and Transfer of Graphene Nanosheets
2.2. Synthesis of Graphene Nanowalls
2.3. Characterizations of Synthesized Graphene Nanostructures
2.3.1. Raman Analysis
2.3.2. SEM and TEM Analysis
2.4. Antibacterial Activity
2.5. Statistical Analysis
3. Results
4. Discussion
5. Conclusions
Author Contributions
Funding
Institutional Review Board Statement
Informed Consent Statement
Data Availability Statement
Acknowledgments
Conflicts of Interest
References
- Yu, Q.; Wu, Z.; Chen, H. Dual-function antibacterial surfaces for biomedical applications. Acta Biomater. 2015, 16, 1–13. [Google Scholar] [CrossRef]
- Aliamradni, V.; Abolmaali, S.S.; Borandeh, S. Antifungal and Antibacterial Properties of Graphene-based Nanomaterials: A Mini-review. J. Nanostruct. 2019, 9, 402–413. [Google Scholar]
- Wei, C.; Lin, W.Y.; Zainal, Z.; Williams, N.E.; Zhu, K.; Kruzic, A.P.; Smith, R.L.; Rajeshwar, K. Bactericidal Activity of TiO2 Photocatalyst in Aqueous Media: Toward a Solar-Assisted Water Disinfection System. Environ. Sci. Technol. 1994, 28, 934–938. [Google Scholar] [CrossRef] [PubMed]
- Kumar, A.; Vemula, P.K.; Ajayan, P.M.; John, G.C. Silver-nanoparticle-embedded antimicrobial paints based on vegetable oil. Nat. Mater. 2008, 7, 236–241. [Google Scholar] [CrossRef]
- Schipper, M.L.; Nakayama-Ratchford, N.; Davis, C.R.; Kam, N.W.S.; Chu, P.; Liu, Z.; Sun, X.; Dai, H.; Gambhir, S.S. A pilot toxicology study of single-walled carbon nanotubes in a small sample of mice. Nat. Nanotechnol. 2008, 3, 216–221. [Google Scholar] [CrossRef] [PubMed]
- Shen, H.; Zhang, L.; Liu, M.; Zhang, Z. Biomedical Applications of Graphene. Theranostics 2012, 2, 283–294. [Google Scholar] [CrossRef] [Green Version]
- Zhang, Q.; Wu, Z.; Li, N.; Pu, Y.; Wang, B.; Zhang, T.; Tao, J. Advanced review of graphene-based nanomaterials in drug delivery systems: Synthesis, modification, toxicity and application. Mater. Sci. Eng. C 2017, 77, 1363–1375. [Google Scholar] [CrossRef]
- Lin, J.; Chen, X.; Huang, P. Graphene-based nanomaterials for bioimaging. Adv. Drug Deliv. Rev. 2016, 105, 242–254. [Google Scholar] [CrossRef] [PubMed] [Green Version]
- Goenka, S.; Sant, V.; Sant, S. Graphene-based nanomaterials for drug delivery and tissue engineering. J. Control. Release 2014, 173, 75–88. [Google Scholar] [CrossRef]
- Tonelli, F.M.P.; Goulart, V.A.M.; Gomes, K.N.; Ladeira, M.S.; Santos, A.K.; Lorençon, E.; Ladeira, L.O.; Resende, R.R. Graphene-based nanomaterials: Biological and medical applications and toxicity. Nanomedicine 2015, 10, 2423–2450. [Google Scholar] [CrossRef]
- Akhavan, O.; Ghaderi, E. Toxicity of Graphene and Graphene Oxide Nanowalls against Bacteria. ACS Nano 2010, 4, 5731–5736. [Google Scholar] [CrossRef]
- Akhavan, O.; Ghaderi, E. Escherichia coli bacteria reduce graphene oxide to bactericidal graphene in a self-limiting manner. Carbon 2012, 50, 1853–1860. [Google Scholar] [CrossRef]
- Al-Thani, R.F.; Patan, N.K.; Al-Maadeed, S. Graphene oxide as antimicrobial against two gram-positive and two gram-negative bacteria in addition to one fungus. Online J. Biol. Sci. 2014, 14, 230–239. [Google Scholar] [CrossRef] [Green Version]
- Liu, S.; Zeng, T.H.; Hofmann, M.; Burcombe, E.; Wei, J.; Jiang, R.; Kong, J.; Chen, Y. Antibacterial Activity of Graphite, Graphite Oxide, Graphene Oxide, and Reduced Graphene Oxide: Membrane and Oxidative Stress. ACS Nano 2011, 5, 6971–6980. [Google Scholar] [CrossRef] [PubMed]
- Pinto, A.M.; Gonçalves, I.; Magalhães, F. Graphene-based materials biocompatibility: A review. Colloids Surf. B 2013, 111, 188–202. [Google Scholar] [CrossRef]
- Geim, A.K.; Novoselov, K.S. Nanoscience and Technology: A Collection of Reviews from Nature Journals; The Rise of Graphene; World Scientific: Singapore, 2010; pp. 11–19. [Google Scholar]
- Jiang, H. Chemical Preparation of Graphene-Based Nanomaterials and Their Applications in Chemical and Biological Sensors. Small 2011, 7, 2413–2427. [Google Scholar] [CrossRef]
- Xiao, F.; Li, Y.; Zan, X.; Liao, K.; Xu, R.; Duan, H. Growth of Metal-Metal Oxide Nanostructures on Freestanding Graphene Paper for Flexible Biosensors. Adv. Funct. Mater. 2012, 22, 2487–2494. [Google Scholar] [CrossRef]
- Efil, E.; Kaymak, N.; Seven, E.; Orhan, E.O.; Bayram, O.; Ocak, S.B.; Tataroglu, A. Current–voltage analyses of Graphene-based structure onto Al2O3/p-Si using various methods. Vacuum 2020, 181, 109654. [Google Scholar] [CrossRef]
- Kaymak, N.; Bayram, O.; Tataroğlu, A.; Ocak, S.B.; Orhan, E.O. Electrical properties of Graphene/Silicon structure with Al2O3 interlayer. J. Mater. Sci. Mater. Electron. 2020, 31, 9719–9725. [Google Scholar] [CrossRef]
- Orhan, E.O.; Efil, E.; Bayram, O.; Kaymak, N.; Berberoğlu, H.; Candemir, O.; Pavlov, I.; Ocak, S.B. 3D-graphene-laser patterned p-type silicon Schottky diode. Mater. Sci. Semicond. Process. 2020, 121, 105454. [Google Scholar] [CrossRef]
- Kaymak, N.; Orhan, E.O.; Bayram, O.; Ocak, S.B. Dielectric characteristics and electrical conductivity behavior of graphene/Al2O3/p-type silicon structure. Mater. Chem. Phys. 2020, 258, 123878. [Google Scholar] [CrossRef]
- Li, J.; Wang, G.; Zhu, H.; Zhang, M.; Zheng, X.; Di, Z.; Liu, X.; Wang, X. Antibacterial activity of large-area monolayer graphene film manipulated by charge transfer. Sci. Rep. 2014, 4, 4359. [Google Scholar] [CrossRef] [Green Version]
- Krishnamoorthy, K.; Veerapandian, M.; Zhang, L.-H.; Yun, K.; Kim, S.J. Antibacterial Efficiency of Graphene Nanosheets against Pathogenic Bacteria via Lipid Peroxidation. J. Phys. Chem. C 2012, 116, 17280–17287. [Google Scholar] [CrossRef]
- Cao, G.; Yan, J.; Ning, X.; Zhang, Q.; Wu, Q.; Bi, L.; Zhang, Y.; Han, Y.; Guo, J. Antibacte-rial and antibiofilm properties of graphene and its derivatives. Colloids Surf. B 2021, 200, 111588. [Google Scholar] [CrossRef] [PubMed]
- Dellieu, L.; Lawarée, E.; Reckinger, N.; Didembourg, C.; Letesson, J.-J.; Sarrazin, M.; Deparis, O.; Matroule, J.-Y.; Colomer, J.-F. Do CVD-grown graphene films have antibacterial activity on metallic substrates? Carbon 2015, 84, 310–316. [Google Scholar] [CrossRef] [Green Version]
- Kumar, P.; Huo, P.; Zhang, R.; Liu, B. Antibacterial Properties of Graphene-Based Nanomaterials. Nanomaterials 2019, 9, 737. [Google Scholar] [CrossRef] [PubMed] [Green Version]
- Avila-Alfaro, J.A.; Sánchez-Valdes, S.; Ramos-Devalle, L.F.; Ortega-Ortiz, H.; Méndez-Nonell, J.; Patiño-Soto, A.P.; Narro-Cespedes, R.I.; Perera-Mercado, Y.A.; Avalosbelmontes, F. Ultrasound Irradiation Coating of Silver Nanoparticle on ABS Sheet Surface. J. Inorg. Organomet. Polym. Mater. 2013, 23, 673–683. [Google Scholar] [CrossRef]
- Karimi, L.; Yazdanshenas, M.E.; Khajavi, R.; Rashidi, A.; Mirjalili, M. Using graphene/TiO2 nanocomposite as a new route for the preparation of electroconductive, self-cleaning, antibacterial, and antifungal cotton fabric without toxicity. Cellulose 2014, 21, 3813–3827. [Google Scholar] [CrossRef]
- Díez-Pascual, A.M.; Díez-Vicente, A.L. Poly(propylene fumarate)/Polyethylene Glycol-Modified Graphene Oxide Nanocomposites for Tissue Engineering. ACS Appl. Mater. Interfaces 2016, 8, 17902–17914. [Google Scholar] [CrossRef]
- Barbiroli, A.; Bonomi, F.; Capretti, G.; Iametti, S.; Manzoni, M.; Piergiovanni, L.; Rollini, M. Antimicrobial activity of lyso-zyme and lactoferrin incorporated in cellulose-based food packaging. Food Control 2012, 26, 387–392. [Google Scholar] [CrossRef] [Green Version]
- Hu, W.; Peng, C.; Luo, W.; Lv, M.; Li, X.; Li, D.; Huang, Q.; Fan, C. Graphene-Based Antibacterial Paper. ACS Nano 2010, 4, 4317–4323. [Google Scholar] [CrossRef] [PubMed]
- Rana, D.; Matsuura, T. Surface Modifications for Antifouling Membranes. Chem. Rev. 2010, 110, 2448–2471. [Google Scholar] [CrossRef] [PubMed]
- Lok, C.-N.; Ho, .C.-M.; Chen, R.; He, Q.-Y.; Yu, W.-Y.; Sun, .H.; Tam, .P.K.-H.; Chiu, J.-F.; Che, C.M. Proteomic Analysis of the Mode of Antibacterial Action of Silver Nanoparticles. J. Proteome Res. 2006, 5, 916–924. [Google Scholar] [CrossRef] [PubMed]
- Ahamed, M.; AlSalhi, M.; Siddiqui, M. Silver nanoparticle applications and human health. Clin. Chim. Acta 2010, 411, 1841–1848. [Google Scholar] [CrossRef] [PubMed]
- Perreault, F.; Faria, A.F.; Nejati, S.; Elimelech, M. Antimicrobial Properties of Graphene Oxide Nanosheets: Why Size Matters. ACS Nano 2015, 9, 7226–7236. [Google Scholar] [CrossRef] [PubMed]
- Ibarra-Alonso, M.; Sanchez-Valdes, S.; Ramírez-Vargas, E.; Fernandez-Tavizón, S.; Romero-Garcia, J.; Ledezma-Pérez, A.; De Valle, L.R.; Rodríguez-Fernández, O.; Espinoza-Martinez, A.; Martínez-Colunga, J.; et al. Preparation and characterization of Polyethylene/Clay/Silver nanocomposites using functionalized polyethylenes as an adhesion promoter. J. Adhes. Sci. Technol. 2015, 29, 1911–1923. [Google Scholar] [CrossRef]
- Pham, V.T.; Truong, V.K.; Quinn, M.D.; Notley, S.M.; Guo, Y.; Baulin, V.A.; Kobaisi, M.A.; Crawford, R.J.; Ivanova, E.P.; Ivanova, E.P. Graphene induces formation of pores that kill spherical and rod-shaped bacteria. ACS Nano 2015, 9, 8458–8467. [Google Scholar] [CrossRef] [PubMed]
- Navarro-Rosales, M.; Ávila-Orta, C.A.; Neira-Velázquez, M.G.; Ortega-Ortiz, H.; Hernández-Hernández, E.; Solís-Rosales, S.G.; Sánchez, B.L.E.; Morones, P.G.; Jiménez, R.; Sánchez-Valdes, S.; et al. Effect of Plasma Modification of Copper Nanoparticles on their Antibacterial Properties. Plasma Process. Polym. 2014, 11, 685–693. [Google Scholar] [CrossRef]
- Bayram, O.; Igman, E.; Guney, H.; Demir, Z.; Yurtcan, M.T.; Cirak, C.; Hasar, U.C.; Simsek, O. Graphene/polyaniline nanocomposite as platinum-free counter electrode material for dye-sensitized solar cell: Its fabrication and photovoltaic performance. J. Mater. Sci. Mater. Electron. 2020, 31, 10288–10297. [Google Scholar] [CrossRef]
- Igman, E.; Bayram, O.; Mavi, A.; Hasar, U.C.; Simsek, O. Photovoltaic performance of non-covalent functionalized single-layer graphene in dye-sensitized solar cells (DSSCs). J. Mater. Sci. 2020, 56, 4184–4196. [Google Scholar] [CrossRef]
- Bayram, O. A study on 3D graphene synthesized directly on Glass/FTO substrates: Its Raman mapping and optical properties. Ceram. Int. 2019, 45, 16829–16835. [Google Scholar] [CrossRef]
- Bayram, O.; Şimşek, O. Vertically oriented graphene nanosheets grown by plasma-enhanced chemical vapor deposition technique at low-temperature. Ceram. Int. 2019, 45, 13664–13670. [Google Scholar] [CrossRef]
- Saeed, M.; Alshammari, Y.; Majeed, S.A.; Al-Nasrallah, E. Chemical Vapour Deposition of Graphene—Synthesis, Characterisation, and Applications: A Review. Molecules 2020, 25, 3856. [Google Scholar] [CrossRef] [PubMed]

| Treatment | E. coli | S. aureus |
|---|---|---|
| Control | 100.00 ± 0.00 a | 100.00 ± 0 a |
| CVD-1 (CVD grown 2D-Monolayer Gr onto glass substrate) | 51.00 ± 3 | 46.50 ± 9 c |
| CVD-2 (CVD grown 2D-1–2 layers Gr onto glass substrate) | 61.50 ± 18 | 75.00 ± 0 b |
| CVD-3 (CVD grown 2D-2–3 layers Gr onto glass substrate) | 90.00 ± 25 ab | 55.50 ± 4 c |
| PECVD-1 (PECVD grown 3D-Gr-100 W onto glass substrate) | 99.50 ± 25 a | 75.00 ± 6 b |
| PECVD-2 (PECVD grown 3D-Gr-150 W onto glass substrate) | 28.50 ± 13 c | 25.00 ± 6 d |
| PECVD-3 (PECVD grown 3D-Gr-200 W onto glass substrate) | 25.50 ± 9 c | 9.50 ± 2 e |
| CVD-1-Ni (CVD grown 2D-Monolayer Gr onto Ni substrate) | 38.00 ± 4 c | 84.50 ± 5 b |
| Sign | ** | ** |
Publisher’s Note: MDPI stays neutral with regard to jurisdictional claims in published maps and institutional affiliations. |
© 2021 by the authors. Licensee MDPI, Basel, Switzerland. This article is an open access article distributed under the terms and conditions of the Creative Commons Attribution (CC BY) license (https://creativecommons.org/licenses/by/4.0/).
Share and Cite
Orhan, E.; Aydın, B.; Açık, L.; Oz, F.; Varzakas, T. Antibacterial Efficiencies of CVD-PECVD Graphene Nanostructures Synthesized onto Glass and Nickel Substrates against Escherichia coli and Staphylococcus aureus Bacteria. Appl. Sci. 2021, 11, 7922. https://doi.org/10.3390/app11177922
Orhan E, Aydın B, Açık L, Oz F, Varzakas T. Antibacterial Efficiencies of CVD-PECVD Graphene Nanostructures Synthesized onto Glass and Nickel Substrates against Escherichia coli and Staphylococcus aureus Bacteria. Applied Sciences. 2021; 11(17):7922. https://doi.org/10.3390/app11177922
Chicago/Turabian StyleOrhan, Elif, Betül Aydın, Leyla Açık, Fatih Oz, and Theodoros Varzakas. 2021. "Antibacterial Efficiencies of CVD-PECVD Graphene Nanostructures Synthesized onto Glass and Nickel Substrates against Escherichia coli and Staphylococcus aureus Bacteria" Applied Sciences 11, no. 17: 7922. https://doi.org/10.3390/app11177922
APA StyleOrhan, E., Aydın, B., Açık, L., Oz, F., & Varzakas, T. (2021). Antibacterial Efficiencies of CVD-PECVD Graphene Nanostructures Synthesized onto Glass and Nickel Substrates against Escherichia coli and Staphylococcus aureus Bacteria. Applied Sciences, 11(17), 7922. https://doi.org/10.3390/app11177922

